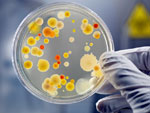

В перинатальном центре ведется монтаж системы освещения
Сегодня заместитель председателя правительства Саратовской области Дмитрий
821

Список "холодных домов" пополнился еще 50 адресами
ИА "Взгляд-инфо" отправило очередной список "холодных домов" Саратова
825

Администрация Саратова: отопление отсутствует в 142 домах
По состоянию на 15.00 сегодняшнего дня, отопление включено в 99,8% объектах
796

Регион накрыла волна "черного PR"
В редакцию "Взгляда-инфо" читатели продолжают присылать печатные
990

Половина россиян не верят в эффективность нового созыва Госдумы
Больше половины россиян считают, что новый созыв Государственной думы
526
СГУ изобрел способ уничтожения микроорганизмов
Саратовский государственный университет получил патент на изобретение
616

В Саратове отремонтируют памятники Ленину и Первой учительнице
Муниципальное бюджетное учреждение "Культурное наследие" объявило открытый
997

ОАО "Саравиа" объявило конкурс на аудит финансовой отчетности
ОАО "Саратовские авиалинии" объявило конкурс на ежегодный аудит годовой
820

Родители похищенной девушки отозвали заявление из полиции
Родители 15-летней ученицы 9-го класса средней школы села Клещевка
744

Вуз отремонтирует "Тойоту Лэнд Крузер", "Мицубиси", "Хундай"
Саратовская государственная юридическая академия (бывшая СГАП) объявила
854

В Саратов едет комиссия Совета Федерации
Саратовскую область посетит комиссия Совета Федерации РФ по жилищной
834

В суд подан иск на владельца сгоревшего дебаркадера
Саратовская межрайонная природоохранная прокуратура завершила проверку
737

Отключение воды в Заводском районе объяснили "работами частного лица"
Сегодня ограничено водоснабжение некоторых абонентов Заводского района
519

Дом на Соборной может остаться зимой без отопления
Сегодня сотрудники Саратовского Госпожнадзора провели рейд по частным
813

Работа комитета облправительства дезорганизована
Многочисленные проверки комитета капитального строительства Саратовской
640

Саратовских школьников навестили звезды сериала "Папины дочки"
1390

В Саратове разрешили "Русский марш". Мнение губернатора
Свое отношение к "Русскому маршу" высказал губернатор Саратовской области
1233

Блоггер Павел Дуксин: "История одного чуда"
С большим удовольствием пишется о хорошем, учитывая, что в последнее
647

Преподаватели "Патриота" выиграли первенство ФСКН РФ
С 18 по 22 октября в Волгограде проходил чемпионат ФСКН России по рукопашному
1080

Глава региона: "Поддерживаю присвоение звания "Город воинской славы"
Губернатор Саратовской области Павел Ипатов поддерживает инициативу
845

Игумен Нектарий рассказывает, зачем "плачут" иконы
На портале Воцерковление.ру опубликована очередная беседа с игуменом
628

Сетевая академия Cisco при СГТУ приглашает на обучение
"Сетевые технологии CISCO" - это авторизованная программа обучения проектированию
590

Мальцев и Бунятов подали встречные заявления в полицию
Пресс-служба ГУ МВД по Саратовской области предоставила нашему агентству
1907

Полиция ждет сообщений о нарушениях во время избирательной кампании
В Управлении МВД России по Саратову начала функционировать "горячая линия"
606

Ипатов не видит "тупиковых проблем" с отопсезоном
Среднемесячная заработная плата в Саратовской области за 9 месяцев текущего
725

Глава региона о стрельбе у "Макдональдса": "Я без оружия"
Постоянные проверки комитета капитального строительства Саратовской области
543

Вячеслав Мальцев против Черкеза Бунятова. Видео поединка
В распоряжении нашего агентства оказались кадры записей с камер видеонаблюдения
6874

В Энгельсе появились фальшивые рубли и доллары
Вчера в Энгельсе Саратовской области в нескольких филиалах ОАО "Сбербанк"
764

Павел Ипатов: "Мы вынуждены идти на дополнительные заимствования"
Губернатор Саратовской области Павел Ипатов "видит абсолютную пассивность"
706

Губернатор о Вячеславе Володине: "Мы – одна команда"
У губернатора Саратовской области Павла Ипатова "деловые" отношения
612

Облсуд прокомментировал процесс по делу о нападении на Малышева
Председатель Саратовского областного суда Василий Тарасов продолжает
1126

Павел Ипатов готовится к встрече с Владимиром Путиным
Губернатор Саратовской области Павел Ипатов готовится к встрече с премьер-министром
918

Сгорело 400 тонн соломы
В селе Ахмат Краснокутского района Саратовской области сгорело 400 тонн
587

Саратовская полиция ищет 15-летнюю Зину Алиян
В Саратовском районе объявлена в розыск 15-летняя ученица 9-го класса
822

Саратовских судей упрекнули в семейственности и регулярных опозданиях
В Саратовском областном суде продолжается встреча главного судьи региона
1083

В ТЮЗе со строительных лесов упала женщина
Вчера в Саратове около 15.00 в здании строящегося Театра юного зрителя
496

В Солнечном совершен разбойный налет на офис ООО
В поселке Солнечный Саратова совершен разбойный налет на офис ООО
541

Общественники критикуют состав квалификационной коллегии судей
В ходе сегодняшней встречи с председателем Саратовского облсуда Василием
923

Саратов исключен из списка самых грязных городов России
Саратов исключен из списка городов России с очень высоким уровнем загрязнения
692

Судами области удовлетворено более половины прошений об УДО
Только что участники встречи с председателем Саратовского областного суда Василием
1016

В Волгу выпустят полмиллиона мальков сазана
Завтра близ села Чардым Воскресенского района Саратовской области в Волгоградское
753

Механизатор лишился пальцев во время уборочной
В августе этого года механизатор Сельскохозяйственного производственного
460

Глава облсуда заявил о "давлении" по делу о дележе власти в Петровске
В эти минуты продолжается встреча председателя Саратовского областного суда
1347

Александр Шваков о трудоустройстве: "Лучше задействовать все свои связи"
Министр занятости, труда и миграции Саратовской области Александр Шваков
867

Василий Тарасов: "Мы видим изменения на своей шкуре"
В эти минуты в здании Саратовского областного суда проходит встреча главного
1351

Состоится концерт академического симфонического оркестра
В воскресенье, 30 октября, Саратовская областная филармония приглашает
739

Кресло главы спорткомитета временно занял Николай Кузнецов
Распоряжением администрации Саратова с 24 октября обязанности начальника
1030

Названа дата переноса московской табачной фабрики в Саратов
Уровень выбросов от Саратовской табачной фабрики ниже установленных
1053

Подозреваемый в убийстве утопил тело жертвы в реке
Вчера в селе Куриловка Новоузенского района Саратовской области сотрудниками
785

Николай Семенец грозится лишить Вольский район финансирования
Депутат Саратовской областной думы, председатель бюджетного комитета
917

Областная прокуратура нуждается в ремонте более 50 автомобилей
Прокуратура Саратовской области объявила электронный аукцион на оказание
872

В Энгельсе без тепла остаются два многоквартирных дома
В Энгельсе Саратовской области подача тепла осуществляется в 813 многоквартирных
626

В Волжском районе перевернулся "Форд Фокус"
Вчера в Волжском районе Саратова на дороге между поселками Юбилейный
585

Сегодня день памяти Святителя Мартина
Святитель Мартин Милостивый, епископ Турский, жил во Франции
686
Главные новости
Стали свидетелем интересного события?
Поделитесь с нами новостью, фото или видео в мессенджерах:
или свяжитесь по телефону или почте




